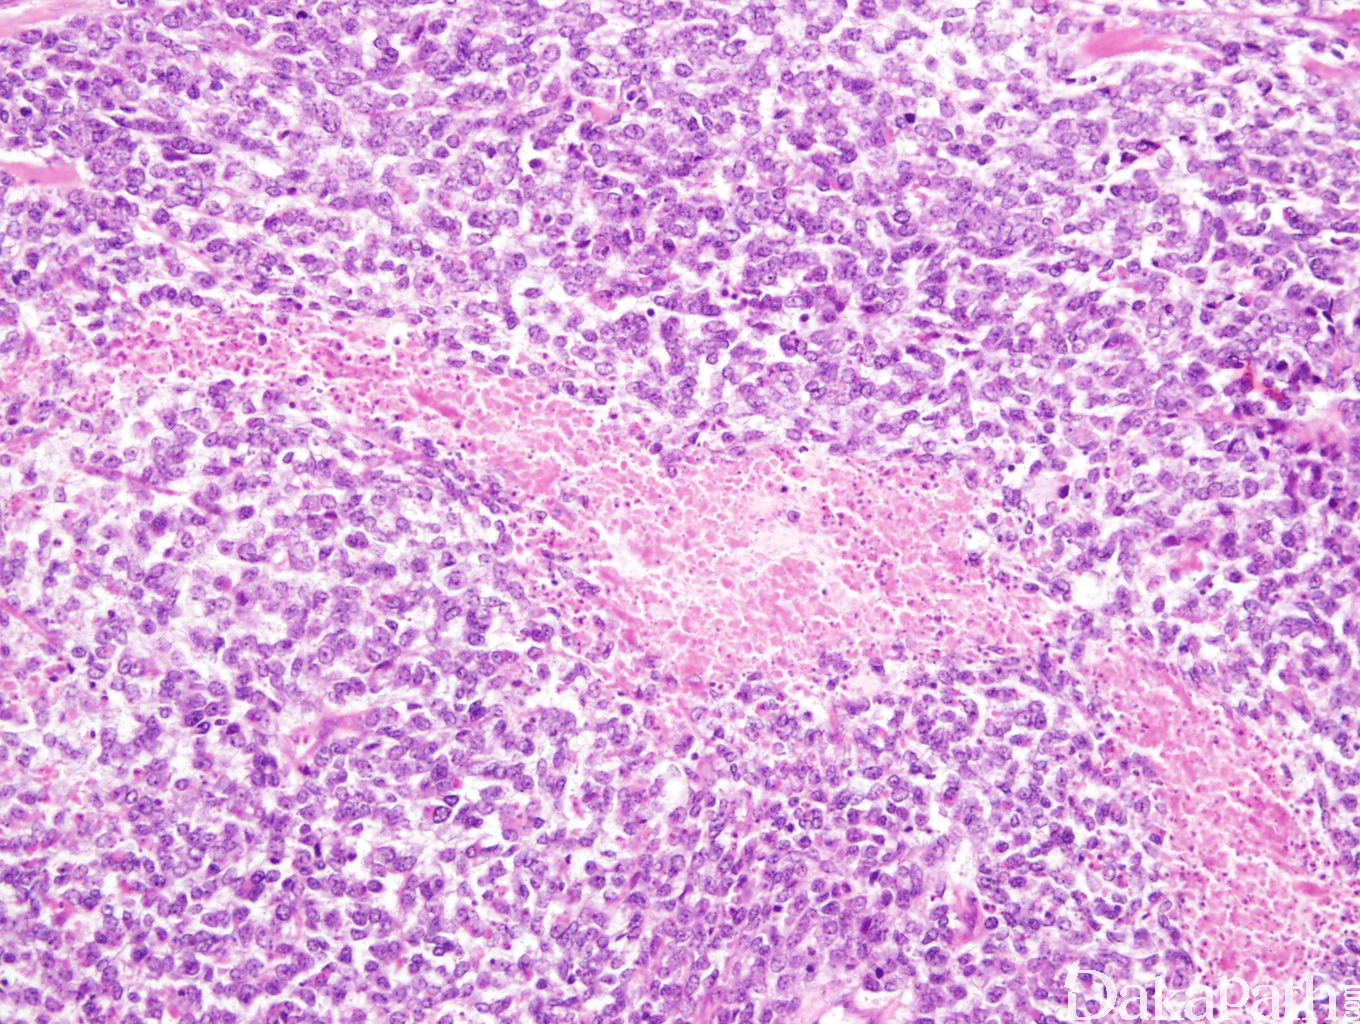

高级别子宫内膜间质肉瘤-伴 YWHAE-NUTM2 基因融合
High Grade Endometrial Stromal Sarcoma with YWHAE-NUTM2 fusion
同义词(或曾用名): 子宫内膜间质肉瘤
概述:
来源于子宫内膜间质的恶性肿瘤,具有高级别圆形细胞形态,常伴有低级别梭形细胞成分。
发病部位: 子宫
诊断要点:
息肉状或子宫内膜肿块,浸润肌层,质软,切面鱼肉状,出血坏死常见;
肿瘤广泛浸润性边缘,浸润灶融合,破坏肌层;
典型的肿瘤细胞呈圆形,大小一致,核 4-6 淋巴细胞大,染色质细腻,核膜不规则, 核分裂像常常 > 10/10 hpfs,非典型核分裂像也可见; 可以伴有低级别梭形细胞成分常伴黏液间质
细胞质:相对少
间质可见纤细的毛细血管网间隔,类似肾脏透明细胞肉瘤
偶尔异型圆形细胞组成假乳头状/腺管状或局灶横纹肌形态,少数病例具原始神经外胚层分化,形成真或假菊型团;
常伴有坏死;
血管侵犯常见;
偶尔只有低级别形态的间质肉瘤也可以伴有 YWHAE-NUTM22 融合
偶尔也可以表现为多形性肉瘤形态
免疫组织化学染色:
高级别和低级别区域有截然不同的免疫组化谱系。 高级别:cyclin D1+ (>70%), BCOR+ (>95%) , ER (-), PR (-), CD10 (-), CD117 (+), DOG1 (-) , p53 野生型 低级别区域:cyclinD1 (-/+), ER (+), PR(+), CD10 (+), CD117 (- 或者局部+), p53 野生型
分子标记:
YWHAE-NUTM2 融合,可以 FISH 或者 PCR
鉴别诊断:
低级别子宫内膜间质肉瘤
平滑肌肉瘤
BCOR 相关性高级别子宫内膜间质肉瘤
高级别多形性未分化肉瘤
治疗:
手术加化疗和/或者放疗
参考文献:
- Lee CH et al. The clinicopathologic features of YWHAE-FAM22 endometrial stromal sarcomas: a histologically high-grade and clinically aggressive tumor. Am J Surg Pathol. 2012 May;36(5):641-53.
- Attygale AD et al. An Unusual Case of YWHAE-NUTM2A/B Endometrial Stromal Sarcoma With Confinement to the Endometrium and Lack of High-Grade Morphology. Int J Gynecol Pathol. 2017 Mar;36(2):165-171.
- Chiang S, Lee CH, Stewart CJR, Oliva E, Hoang LN, Ali RH, Hensley ML, Arias-Stella JA 3rd, Frosina D, Jungbluth AA, et al. BCOR is a robust diagnostic immunohistochemical marker of genetically diverse high-grade endometrial stromal sarcoma, including tumors exhibiting variant morphology. Mod Pathol. 2017 Sep; 30(9):1251-1261.